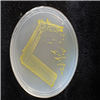

Korean Collection for Type Cultures
KCTC provides the distribution services
Find Resources
KCTC 52606
| KCTC No. | 52606 |
|---|---|
| (KCTC Other No.) | |
| Resource Type | Bacteria |
| Name | Altererythrobacter lauratis |
| Type Strain | Yes |
| Biosafty Level | 1 |
| LMO | No |
| Synonym | |
| Phylum (ex Phylum) | Pseudomonadota (Proteobacteria - Alphaproteobacteria) |
| Genome Information | |
| History | <- Wen-jun Li, Yunnan Institute of Microbiology |
| Source | From the sediment of hot spring, Tagejia geothermal's hot spring of Tibet |
| Other Collection No. | CCTCC [AB2016268] |
| Reference | 10.1007/s10482-017-0882-y |
| KCTC Media No. |
KCTC media No. 493 R2A agar medium |
| Oxygen Requirement | Aerobic |
| Temperature | 37~45 ℃ |
| pH | netural pH 배양 가능 (배지정보 참조) |
| Incubation Time | 5 d [활성상태 계대배양 기준이므로 앰퓰, 스탁 등 장기보존체 배양의 경우 다를 수 있음] |
| Images |
|
| Price |
[Delivery form & Price]
- Freeze vial (Regular distribution): $70,000 KRW - Actively growing culture (Active culture distribution): ₩105 KRW * For regular distribution of animal cell strains to other countries, a separate dry ice fee (packing charges $500) will be added. ※ If you are picking up an animal cell strain in person, you must bring your own dry ice or liquid nitrogen. |
| MTA Restrictions | Only NON-COMMERCIAL USE for reference strains and/or academic researches |
If you use the resources sold by our KCTC for papers or patents, please make sure to write the phrase "The biological resources used in this research were distributed from KCTC"
 References
References
| Title | Jounal | Issued |
|---|---|---|
| Altererythrobacter lauratis sp. nov. and Altererythrobacter palmitatis sp. nov., isolated from a Tibetan hot spring | Springer | 2017 |




